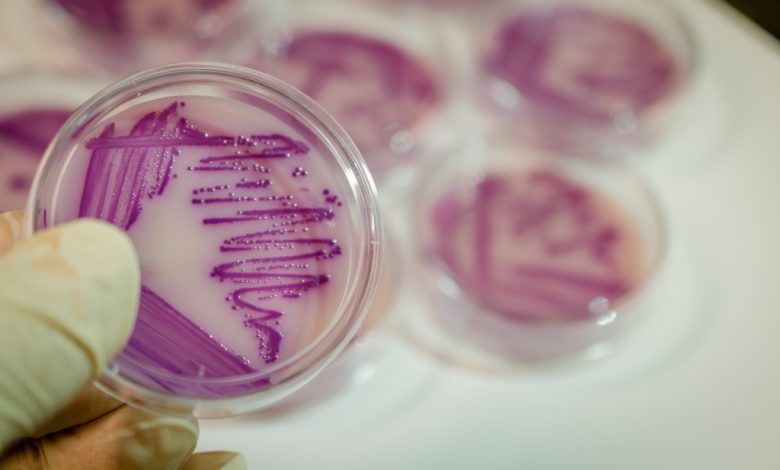

Brasil regista primeiras mortes por doença bacteriana transmitida pela água nas inundações
O Brasil registou duas mortes por leptospirose, uma doença bacteriana transmitida pela água, no estado do Rio Grande do Sul, que sofre de inundações sem precedentes, indicaram hoje as autoridades de saúde.
![]()
![]()
A Secretaria Estadual da Saúde do Rio Grande do Sul confirmou, em comunicado, “o segundo óbito por leptospirose relacionado às enchentes no Rio Grande do Sul”.
Trata-se de um homem de 33 anos que morreu na sexta-feira, tendo a causa da morte sido confirmada hoje após o resultado positivo na amostra em laboratório.
Na segunda-feira, as autoridades já haviam confirmado a primeira morte por leptospirose, num homem de 67 anos.
“Mesmo que a leptospirose seja uma doença endémica, com circulação sistemática, episódios como a dos alagamentos aumentam a chance de infeção. Por isso é importante que a população procure um serviço de saúde logo nos primeiros sintomas: febre, dor de cabeça, fraqueza, dores no corpo (em especial, na panturrilha) e calafrios”, avisaram as autoridades regionais.
As equipas da organização Médicos Sem Fronteiras (MSF) descrevem como catastrófica a situação humanitária deixada pelas inundações no Rio Grande do Sul, cujo impacto estimam como irreparável, com mais de 150 mortos e cerca de 100 desaparecidos.
“A situação é catastrófica. Quando chegámos e percorremos a região de helicóptero, pudemos ver as cidades de cima e reparámos que, em alguns casos, não conseguíamos sequer ver os telhados das casas. São quilómetros e quilómetros, e tudo o que há é água”, descreve a coordenadora médica dos MSF, Rachel Soeiro, num comunicado hoje divulgado pela organização não-governamental.
As chuvas extremas e as enchentes que atingiram o estado do Rio Grande do Sul isolaram e forçaram a evacuação de cidades inteiras, as estradas foram destruídas, pontes derrubadas e o principal aeroporto da capital, Porto Alegre, está fechado por tempo indeterminado.
Mais de 460 municípios, de um total de 497 do estado, foram atingidos, mais de dois milhões de pessoas foram afetadas e mais de 600 mil deslocadas das suas casas, para abrigos improvisados, sem saber quando poderão regressar, segundo dados oficiais.
As equipas de emergência dos MSF estão concentradas nas populações mais vulneráveis, que “já enfrentavam situações difíceis antes das enchentes”, mas cujas necessidades “aumentaram”, ao mesmo tempo que o acesso a elas se tornou “mais difícil”, segundo Rachel Soeiro.
“Visitámos comunidades indígenas como Guajayvi e Kurity, nos municípios de Charqueadas e Canelas. Numa das ocasiões, a população estava totalmente isolada pela subida das águas e sem ajuda há mais de dez dias”, anunciou a organização.
Os MSF montaram duas clínicas móveis com equipas de médicos, enfermeiros, psicólogos e promotores de saúde na cidade de Canoas, na região metropolitana de Porto Alegre, e está a dar consultas médicas à distância, além de oferecer formação sobre primeiros socorros em saúde mental a profissionais que estão no terreno a ajudar as vítimas das cheias.
O cenário na região é ainda muito vulnerável, face ao clima instável, que pode causar novas inundações ou atrasar o regresso das pessoas às suas casas.
LUSA/HN
Outros artigos com interesse:



